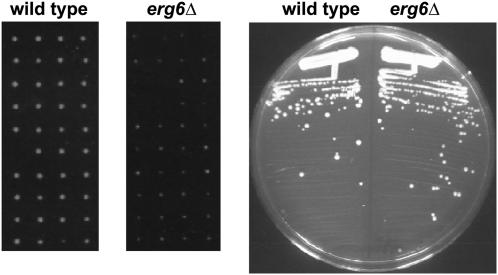
https://cdn.ncbi.nlm.nih.gov/pmc/blobs/50d9/3276131/d467796fc5f4/143f5.jpg

在酿酒酵母中筛选萌发突变体。
A Screen for Germination Mutants in Saccharomyces cerevisiae.
机构信息
Department of Genetics, Harvard Medical School, Boston, Massachusetts 02115.
出版信息
G3 (Bethesda). 2011 Jul;1(2):143-9. doi: 10.1534/g3.111.000323. Epub 2011 Jul 1.
Spore germination in Saccharomyces cerevisiae is a process in which a quiescent cell begins to divide. During germination, the cell undergoes dramatic changes in cell wall and membrane composition, as well as in gene expression. To understand germination in greater detail, we screened the S. cerevisiae deletion set for germination mutants. Our results identified two genes, TRF4 and ERG6, that are required for normal germination on solid media. TRF4 is a member of the TRAMP complex that, together with the exosome, degrades RNA polymerase II transcripts. ERG6 encodes a key step in ergosterol biosynthesis. Taken together, these results demonstrate the complex nature of germination and two genes important in the process.
酿酒酵母的孢子萌发是一个休眠细胞开始分裂的过程。在萌发过程中,细胞的细胞壁和膜组成以及基因表达发生了显著变化。为了更详细地了解萌发过程,我们筛选了酿酒酵母缺失体库中的萌发突变体。我们的结果确定了两个基因 TRF4 和 ERG6,它们是在固体培养基上正常萌发所必需的。TRF4 是 TRAMP 复合物的成员之一,与核酶复合物一起降解 RNA 聚合酶 II 转录本。ERG6 编码甾醇生物合成中的关键步骤。这些结果共同证明了萌发过程的复杂性和该过程中两个重要基因的作用。